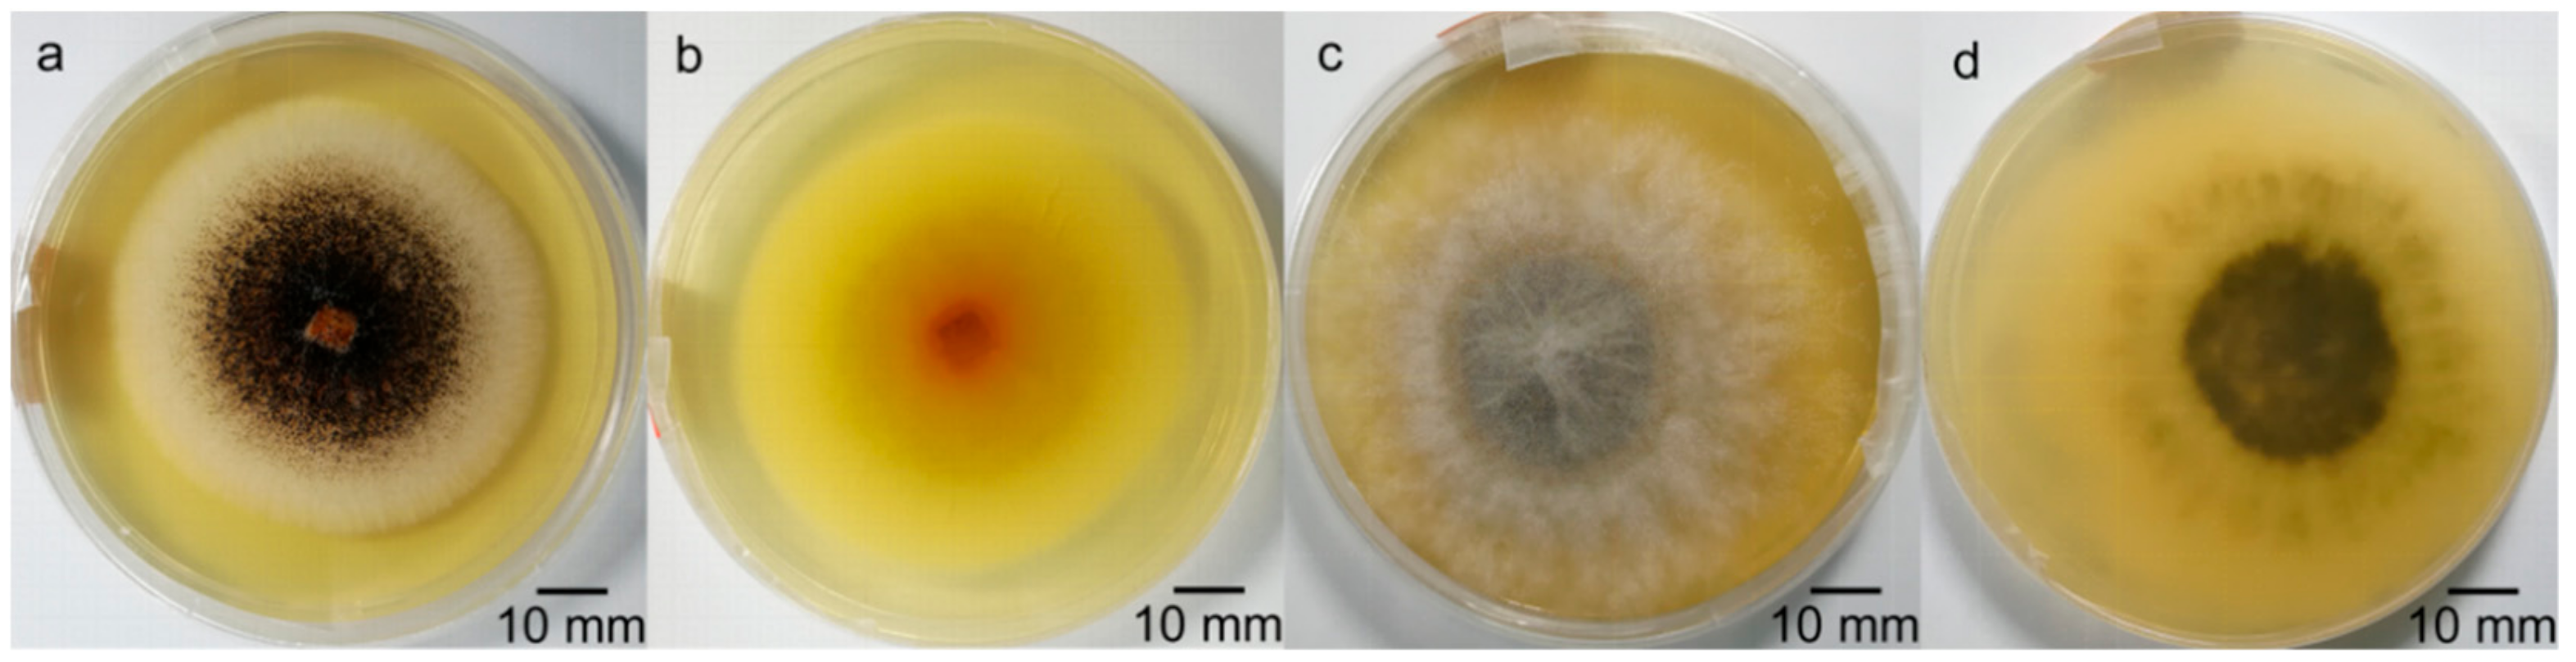

Identification the Pathogens Causing Rot Disease in Pomegranate (Punica granatum L.) in China and the Antifungal Activity of Aqueous Garlic Extract
Abstract
1. Introduction
2. Materials and Methods
2.1. Plant Material
2.2. Pathogen Isolation
2.3. Identification of the Pathogens by Koch’s Postulates
2.4. Morphological Identification of Pathogens
2.5. DNA Extraction
2.6. Polymerase Chain Reaction (PCR) and Sequencing
2.7. Pathogenicity Test
2.8. Antifungal Assays
2.9. Statistical Analysis
3. Results
3.1. Observation of the Rot Symptoms
3.2. Pathogenicity Identification of the Pathogens
3.3. Morphological Identification of the Pathogens
3.4. Molecular Biology Identification
3.5. Pathogenicity Test
3.6. Antifungal Assays
3.7. Mycelium Growth Rate of the Two Pathogens under Different Concentrations of Aqueous Garlic Extract
4. Discussion
5. Conclusions
Supplementary Materials
Author Contributions
Funding
Acknowledgments
Conflicts of Interest
References
- Sun, D.M. Occurrence of Dry Rot Zythia Versoniana Sacc and Its Control in Shaanxi. Master’s Thesis, Northwest A&F University, Yangling, Xianyang, China, 2 June 2008. [Google Scholar]
- Thomas, T. Fruit rots of pomegranate (cv. Wonderful) in Greece. Australas. Plant Path. 2014, 43, 583–588. [Google Scholar]
- Wang, R.; Ding, Y.; Liu, R.; Xiang, L.; Du, L. Pomegranate: Constituents, bioactivities and pharmacokinetics. Fruit Veg. Cereal Sci. Biotechnol. 2010, 4, 77–87. [Google Scholar]
- Borochov-Neori, H.; Judeinstein, S.; Tripler, E.; Harari, M.; Greenberg, A.; Shomer, I.; Holland, D. Seasonal and cultivar variations in antioxidant and sensory quality of pomegranate (Punica granatum L.) fruit. J. Food Compos. Anal. 2009, 22, 189–195. [Google Scholar] [CrossRef]
- Miguel, M.G.; Neves, M.A.; Antunes, M.D. Pomegranate (Punica granatum L.): A medicinal plant with myriad biological properties—A short review. J. Med. Plants Res. 2010, 4, 2836–2847. [Google Scholar]
- Syed, D.N.; Afaq, F.; Mukhtar, H. Pomegranate derived products for cancer chemoprevention. Semin. Cancer Biol. 2007, 17, 377–385. [Google Scholar] [CrossRef] [PubMed]
- Singh, R.; Chandrashekharappa, S.; Bodduluri, S.R.; Baby, B.V.; Hegde, B.; Kotla, N.G.; Hiwale, A.A.; Saiyed, T.; Patel, P.; Vijay-Kumar, M.; et al. Enhancement of the gut barrier integrity by a microbial metabolite through the Nrf2 pathway. Nat. Commun. 2019, 10, 89. [Google Scholar] [CrossRef]
- Tedford, E.C.; Adaskaveg, J.E.; Ott, A.J. Impact of Scholar (a new post-harvest fungicide) on the California pomegranate industry. Plant Health Prog. 2005, 10, 94. [Google Scholar] [CrossRef]
- Fu, J.N.; Liu, X.H.; Cai, F.D.; Kou, L.P. Identification of pathogenic fungus causing a decay of stored pomegranate fruits using molecular biology technique. Acta Hortic. Sin. 2007, 34, 877–882. [Google Scholar]
- Mirabolfathy, M.; Groenewald, J.Z.; Crous, P.W. First report of Pilidiella granati causing dieback and fruit rot of pomegranate (Punica granatum) in Iran. Plant Dis. 2012, 96, 461. [Google Scholar] [CrossRef]
- Yao, X. Study on Postharvest Quality Deterioration and Control Technology of Pomegranate. Ph.D. Thesis, Sichuan Agriculture University, Chengdu, China, 12 June 2017. [Google Scholar]
- Schoch, C.L.; Seifert, K.A.; Huhndorf, S.; Robert, V.; Spouge, J.L.; Levesque, C.A.; Chen, W.; Bolchacova, E.; Voigt, K.; Crous, P.W.; et al. Nuclear ribosomal internal transcribed spacer (ITS) region as a universal DNA barcode marker for fungi. Proc. Natl. Acad. Sci. USA 2012, 109, 6241–6246. [Google Scholar] [CrossRef]
- Geiser, D.M.; Klich, M.A.; Frisvad, J.C.; Peterson, S.W.; Varga, J.; Samson, R.A. The current status of species recognition and identification in Aspergillus. Stud. Mycol. 2007, 59, 1–10. [Google Scholar] [CrossRef] [PubMed]
- Borlinghaus, J.; Albrecht, F.; Gruhlke, M.; Nwachukwu, I.; Slusarenko, A. Allicin: Chemistry and biological properties. Molecules 2014, 19, 12591–12618. [Google Scholar] [CrossRef] [PubMed]
- Houshmand, B.; Mahjour, F.; Dianat, O. Antibacterial effect of different concentrations of garlic (Allium sativum) extract on dental plaque bacteria. Indian J. Dent. Res. 2013, 24, 71. [Google Scholar] [PubMed]
- Pakdel, F.; Ghasemi, S.; Babaloo, A.; Javadzadeh, Y.; Fathi, F.Y. Antibacterial Effects of Garlic Extracts and Ziziphora Essential Oil on Bacteria Associated with Peri-Implantitis. J. Clin. Diagn. Res. 2017, 11, ZC16–ZC19. [Google Scholar] [CrossRef]
- Burian, J.P.; Sacramento, L.V.S.; Carlos, I.Z. Fungal infection control by garlic extracts (Allium sativum L.) and modulation of peritoneal macrophages activity in murine model of sporotrichosis. Braz. J. Biol. 2017, 77, 848–855. [Google Scholar] [CrossRef][Green Version]
- Silva, D.M.; Batista, L.R.; Rezende, E.F.; Fungaro, M.H.P.; Sartori, D. Identification of fungi of the genus Aspergillus section Nigri using polyphasic taxonomy. Braz. J. Microbiol. 2011, 42, 761–773. [Google Scholar] [CrossRef]
- Marsberg, A.; Kemler, M.; Jami, F.; Nagel, J.H.; Postma-Smidt, A.; Naidoo, S.; Wingfield, M.J.; Crous, P.W.; Spatafora, J.W.; Hesse, C.N.; et al. Botryosphaeria dothidea: A latent pathogen of global importance to woody plant health. Mol. Plant Pathol. 2017, 18, 477–488. [Google Scholar] [CrossRef]
- Slippers, B.; Crous, P.W.; Denman, S.; Coutinho, T.A.; Wingfield, B.D.; Wingfield, M.J. Combined multiple gene genealogies and phenotypic characters differentiate several species previously identified as Botryosphaeria dothidea. Mycologia 2004, 96, 83–101. [Google Scholar] [CrossRef]
- Zhang, Y.J.; Zhang, S.; Liu, X.Z.; Wen, H.A.; Wang, M. A simple method of genomic DNA extraction suitable for analysis of bulk fungal strains. Lett. Appl. Microbiol. 2010, 51, 114–118. [Google Scholar] [CrossRef]
- White, T.J.; Bruns, T.D.; Lee, S.; Taylor, J. Amplification and direct sequencing of fungal ribosomal RNA genes for phylogenetics. In PCR Protocols: A Guide to Methods and Applications; Michael, A.I., David, H.G., John, J.S., White, T.J., Eds.; Academic Press: New York, NY, USA, 1989; pp. 315–322. [Google Scholar]
- Xu, P.; Han, Y.; Wu, J.; Lv, H.; Qiu, L.; Chang, R.; Jin, L.; Wang, J.; Yu, A.; Chen, C.; et al. Phylogenetic analysis of the sequences of rDNA internal transcribed spacer (ITS) of Phytophthora sojae. J. Genet. Genomics 2007, 34, 180–188. [Google Scholar] [CrossRef]
- Saitou, N.; Nei, M. The neighbor-joining method: A new method for reconstructing phylogenetic trees. Mol. Biol. Evol. 1987, 4, 406–425. [Google Scholar] [PubMed]
- Tamura, K.; Nei, M.; Kumar, S. Prospects for inferring very large phylogenies by using the neighbor-joining method. Proc. Natl. Acad. Sci. USA 2004, 101, 11030–11035. [Google Scholar] [CrossRef] [PubMed]
- Shen, Y. Screening and Identification of Endophytic Actinomycetes from Maize and Research on the Mechanism of Antifungal Activity against Exserohilum Turcicum. Ph.D. Thesis, Northeast Agricultural University, Harbin, China, June 2014. [Google Scholar]
- Song, X.H.; Sun, D.M.; Wang, M.G.; Ma, Q. Occurrence of the pomegranate fruit rot and identification of its pathogen. Acta Phytophylacica Sin. 2011, 38, 93–94. [Google Scholar]
- Tziros, G.T.; Tzavella-Klonari, K. Pomegranate fruit rot caused by Coniella granati confirmed in Greece. Plant Pathol. 2008, 57, 783. [Google Scholar] [CrossRef]
- Suleiman, E.; Abdallah, W. In vitro activity of garlic (Allium sativum) on some pathogenic fungi. Eur. J. Med. Plants 2014, 4, 1240–1250. [Google Scholar] [CrossRef]
- Irkin, R.; Korukluoglu, M. Control of Aspergillus niger with garlic, onion and leek extracts. Afr. J. Biotechnol. 2007, 6, 384–387. [Google Scholar]
- Pai, S.T.; Platt, M.W. Antifungal effect of Allium sativum (garlic) extract against the Aspergillus species involved in otomycosis. Lett. Appl. Microbiol. 1995, 20, 14–18. [Google Scholar] [CrossRef]
- Cobos, R.; Rosa, M.M.; José, M.Á.-P.; Olego, M.A.; Juan, J.R.C. Effectiveness of natural antifungal compounds in controlling infection by grapevine trunk disease pathogens through pruning wounds. Appl. Environ. Microbiol. 2015, 81, 6474–6483. [Google Scholar] [CrossRef]
- Abdulaziz, B.K.; Musa, D.D.; Aisha, H. Antifungal activity of garlic (Allium sativum) extract on some selected fungi. J. Med. Herbs Ethnomed. 2018, 4, 12–14. [Google Scholar]
- Irkin, R.; Korukluoglu, M. Control of Some Filamentous Fungi and Yeasts by Dehydrated Allium Extracts. J. Verbr. Lebensm. 2009, 4, 3–6. [Google Scholar] [CrossRef]
- Marchese, A.; Barbieri, R.; Sanches-Silva, A.; Daglia, M.; Nabavi, S.F.; Jafari, N.J.; Izadi, M.; Ajami, M.; Nabavi, S.M. Antifungal and antibacterial activities of allicin: A review. Trends Food Sci. Technol. 2016, 52, 49–56. [Google Scholar] [CrossRef]

© 2019 by the authors. Licensee MDPI, Basel, Switzerland. This article is an open access article distributed under the terms and conditions of the Creative Commons Attribution (CC BY) license (http://creativecommons.org/licenses/by/4.0/).
Share and Cite
Li, X.; Lu, X.; He, Y.; Deng, M.; Lv, Y. Identification the Pathogens Causing Rot Disease in Pomegranate (Punica granatum L.) in China and the Antifungal Activity of Aqueous Garlic Extract. Forests 2020, 11, 34. https://doi.org/10.3390/f11010034
Li X, Lu X, He Y, Deng M, Lv Y. Identification the Pathogens Causing Rot Disease in Pomegranate (Punica granatum L.) in China and the Antifungal Activity of Aqueous Garlic Extract. Forests. 2020; 11(1):34. https://doi.org/10.3390/f11010034
Chicago/Turabian StyleLi, Xingqi, Xinyue Lu, Yiheng He, Mengting Deng, and Yanrong Lv. 2020. "Identification the Pathogens Causing Rot Disease in Pomegranate (Punica granatum L.) in China and the Antifungal Activity of Aqueous Garlic Extract" Forests 11, no. 1: 34. https://doi.org/10.3390/f11010034
APA StyleLi, X., Lu, X., He, Y., Deng, M., & Lv, Y. (2020). Identification the Pathogens Causing Rot Disease in Pomegranate (Punica granatum L.) in China and the Antifungal Activity of Aqueous Garlic Extract. Forests, 11(1), 34. https://doi.org/10.3390/f11010034
